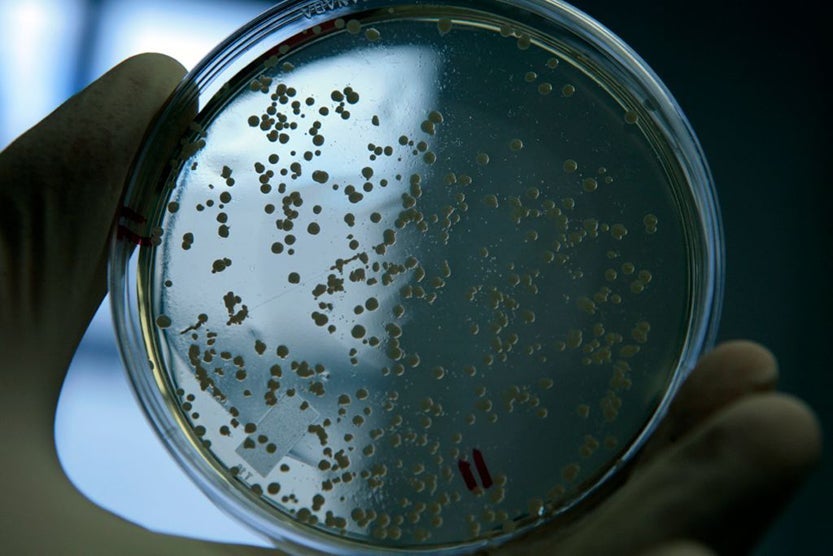

Why You'll Want to Change Your Socks After Airport Security
There's only one thing that Mack, an emergency-room doctor in a major US city, always makes sure he brings with him to the airport, in addition to his passport: an extra pair of socks.
As soon as he passes through the TSA security screening, he picks up his stuff, sits down at a nearby bench and digs through his backpack for those socks. Then — before he slips his cordovan clogs back on — he takes off his old socks and puts on the new ones.
"You don't want to know what you can catch," Mack says when you ask him what the deal is. "You don't want to know."
(Mack, if it isn't obvious, isn't his real name. He asked that we use a pseudonym because of his position.)
Actually, we did want to know, so we asked around. What we found is enough to make your toes curl.
Fungi
If you were to catch something walking shoeless through airport security, the most likely suspect is a fungal infection, specifically tinea pedis, better known as athlete's foot (on other parts of the body it's called ringworm). The invader is a fungus called Trichophyton rubrum, an organism native to Southeast Asia that didn't appear in the US until the 1920s in Birmingham, Alabama, when former doughboys back from World War I are believed to have brought the disease home from Europe. Now it's estimated that one in every five Americans is itching from it this very second.
There's a reason it's the most prevalent fungal infection among humans in the world: Given the right conditions, it's really easy to catch. Requiring only skin contact with an object that's been infected by another person with the fungus — a towel, clothing, carpet or damp floor — the fungal spores thrive in hot, humid places but can also survive long enough on surfaces with frequent foot traffic to infect unsuspecting people. (Some dermatophytes can survive for an entire year once they've established themselves in the right spot.)
"In a high-traffic area, the number of people per hour going through a checkpoint is greater at an airport than at a health club," Dr. Michael J. Trepal, vice president for academic affairs and dean at the New York College of Podiatric Medicine, said in a phone interview. "And, theoretically, the more you expose the skin to exogenous pathogens, the more likely you are to be infected. In some cases, you could realistically walk 30 to 40 feet [without shoes]."
Of course, if the airport's as hot and humid as a locker room, you may be doomed anyway: Socks won't necessarily protect you from the spores.
The result? Intensely itchy, burning, scaly skin, especially between the toes, sometimes leading to even more weeping blisters and painful fissures in the skin. It can be treated with widely available antifungal sprays and creams, but it's never fun to contract.

Viruses
The virus your feet should be most afraid of while walking through airport security bereft of protection is the one that causes plantar warts. Yes, certain strains of the human papilloma virus aren't just surprise gifts from the worst date you ever had. These forms of HPV enter the body through cuts and breaks in the skin (as opposed to through sexual contact, like the more infamous strains) and form unsightly warts on the bottom of the foot. Sometimes the warts are painful, sometimes they're merely irritating. Either way, they can take years to go away, and most treatments are only successful about half the time. If you're impatient, a doctor may try to freeze the wart off with liquid nitrogen.
As with Trichophyton rubrum, HPV doesn't live for long outside of a human host, but the unusual circumstances of a TSA checkpoint — a long line of shoeless strangers forced to walk in quick succession through the same narrow checkpoint over the same seedy-looking rectangle of floor — could turn an airport into HPV happy hour. (You can also get it at pools, locker rooms and the like.)

Bacteria
Here's where it gets really scary. People with compromised immune systems or with breaks in the skin on their feet could be vulnerable to some especially nasty stuff. The big concern? Methicillin-resistant Staphylococcus aureus, or MRSA (pronounced "mersa"), often nicknamed "the superbug" by the media. It's a kind of staph infection that's troublingly resistant to antibiotics and is becoming increasingly more common since the community-associated version first reared its ugly head in the 1990s.
Once again, it's people with breaks in the skin on their feet, those with immune deficiencies and those with poor circulation who are most at risk at the airport. Someone with a MRSA infection could pass the bacteria onto the floor or rug at a TSA checkpoint, where one of the people following him could pick up the bug through a cut.
A CA-MRSA infection normally looks like a boil or abscess and can be quite painful. In more serious cases, though, MRSA can lead to sepsis, bloodstream infections and pneumonia, all of them potentially fatal.
And MRSA's not the only foot-related bacteria to be worried about at airport security.
"Theoretically, you could pick up a wide variety of bacteria under the skin," Trepal said. "If you had a break in the skin, one of them could gain entry and set off an infection. And a skin infection of the foot could become a systemic infection, too."
How to Prevent All That Stuff
There hasn't been much in the way of published studies looking at disease transmission at airport security, though the TSA commissioned a 2003 study that said the chances of infection while walking through a checkpoint without shoes are "extremely small to remote" when the floor isn't moist. And Trepal emphasized that it's not really clear yet how easily an airport security checkpoint lends itself to transmitting diseases.
"You're probably at a bigger risk of contracting something on your hands, because you're touching stair rails, escalator rails and countertops at the airport for much longer than your feet are walking through security," he said.
But he also said the ways to prevent any infection, whether fungal, viral or bacterial, are largely the same and boil down to common sense and a little discipline.
"It just goes to good bodily hygiene, like washing your hands," he said. "Try to minimize barefoot contact with foreign surfaces, and try to wear socks [inside your shoes] if you want an extra level of precaution."
If you have an open wound or cut on your foot, take the same precautions walking through an airport that you would strolling through the park: Put a bandage on it and keep it clean.
And Dr. Mack's second pair of socks? They do make sense, Trepal said, if you're worried about an infected pair of socks transferring a harmful organism or virus onto your skin or the inside of your shoe.
"Theoretically, yes, the sock is a protective barrier and protects the skin, but if you wear the sock on the floor and it picks up something, yes," he said. "There's certainly no harm in changing your socks."
But Trepal said he himself practices the safest preventative measure of all.
"I have TSA PreCheck now," he said. "I don't have to take my shoes off."
TPG featured card
at American Express's secure site
Terms & restrictions apply. See rates & fees.
| 4X | Earn 4X Membership Rewards® points per dollar spent on purchases at restaurants worldwide, on up to $50,000 in purchases per calendar year, then 1X points for the rest of the year. |
| 4X | Earn 4X Membership Rewards® points per dollar spent at US supermarkets, on up to $25,000 in purchases per calendar year, then 1X points for the rest of the year. |
| 5X | New! Earn 5X Membership Rewards® points on prepaid hotel stays booked through AmexTravel.com or the Amex Travel App. |
| 3X | Earn 3X Membership Rewards® points on flights booked through AmexTravel.com, the Amex Travel App, or purchased directly from airlines. |
| 2X | Earn 2X Membership Rewards® points on prepaid car rentals booked through AmexTravel.com or the Amex Travel App and cruises booked and paid through AmexTravel.com. |
| 1X | Earn 1X Membership Rewards® point per dollar spent on all other eligible purchases. |
Pros
- Valuable dining and food-related credits
- Flexible rewards with airline and hotel transfer partners
- Multiple travel and purchase protections
- No foreign transaction fees
- Access to Amex Offers for additional savings (enrollment required)
Cons
- Not as useful for those living outside the U.S.
- Some may have trouble using Uber and other dining credits
- You may be eligible for as high as 100,000 Membership Rewards® Points after you spend $8,000 in eligible purchases on your new Card in your first 6 months of Card Membership. Welcome offers vary and you may not be eligible for an offer. Apply to know if you’re approved and find out your exact welcome offer amount – all with no credit score impact. If you’re approved and choose to accept the Card, your score may be impacted.
- Earn 4X Membership Rewards® points per dollar spent on purchases at restaurants worldwide, on up to $50,000 in purchases per calendar year, then 1X points for the rest of the year.
- Earn 4X Membership Rewards® points per dollar spent at US supermarkets, on up to $25,000 in purchases per calendar year, then 1X points for the rest of the year.
- New! Earn 5X Membership Rewards® points on prepaid hotel stays booked through AmexTravel.com or the Amex Travel App.
- Earn 3X Membership Rewards® points on flights booked through AmexTravel.com, the Amex Travel App, or purchased directly from airlines.
- Earn 2X Membership Rewards® points on prepaid car rentals booked through AmexTravel.com or the Amex Travel App and cruises booked and paid through AmexTravel.com.
- Earn 1X Membership Rewards® point per dollar spent on all other eligible purchases.
- Pay It® lets you tap in the American Express® App to quickly pay for small purchase amounts throughout the month and still earn rewards the way you usually do. Plan It® gives you the option to split up big purchases into equal monthly payments with a fixed fee. You’ll know upfront exactly how much you’ll pay.
- Updated! $120 Dining Credit: Earn up to a total of $10 in statement credits monthly when you pay with the Gold Card at Grubhub (including Seamless), Buffalo Wild Wings, Five Guys, The Cheesecake Factory, and Wonder. This can be an annual savings of up to $120. Enrollment required.
- $100 Resy Credit: Get up to $100 in statement credits each calendar year at over 10,000 qualifying U.S. Resy restaurants after you pay for eligible purchases with the American Express® Gold Card. That’s up to $50 in statement credits semi-annually. Enrollment required.
- $84 Dunkin' Credit: Earn up to $7 in monthly statement credits after you pay with the American Express® Gold Card at U.S. Dunkin’ locations. Enrollment required.
- $120 Uber Cash on Gold: Enjoy up to $120 in Uber Cash annually with your Gold Card. Just add your Card to your Uber account and you'll get $10 in Uber Cash each month to use on orders and rides in the U.S. when you select an Amex Card for your transaction.
- New! As an American Express® Gold Card Member, you can enjoy complimentary Hertz Five Star® Status. Enjoy benefits like skipping the counter at select locations, adding an additional driver at no additional cost*, and vehicle upgrades**. Benefit enrollment and Hertz Gold+ registration are required. *Additional drivers must meet standard rental qualifications and must be a spouse or domestic partner to qualify as complimentary. Other additional drivers subject to fees. **Benefits are subject to availability and vary by location. Additional Hertz program Terms and Conditions including age restrictions apply.
- Take advantage of a $100 credit towards eligible charges* at over 1,300 upscale hotels worldwide when you book The Hotel Collection through AmexTravel.com or the Amex Travel App **. *Eligible charges vary by property. **The Hotel Collection requires a two-night minimum stay.
- Book your travel through the Amex Travel App with added peace of mind – backed by American Express® service and support. Only for American Express® Card Members.
- Whenever you need us, we're here. Our Member Services team will ensure you are taken care of. From lost Card replacement to statement questions, we are available to help 24/7.
- No Foreign Transaction Fees.
- Annual Fee is $325.
- Terms Apply.


